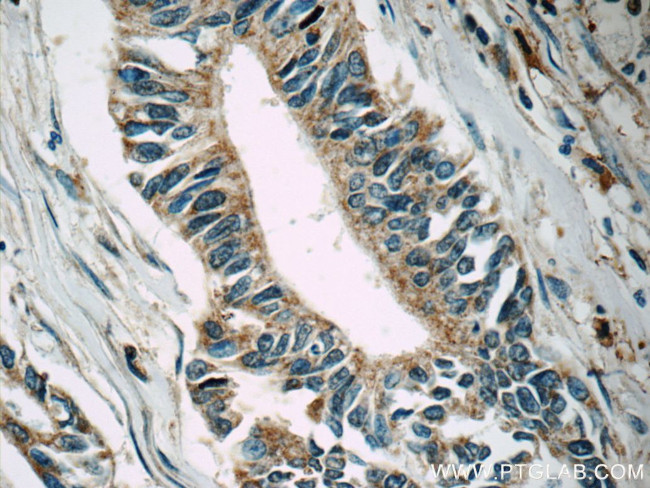
MLK2 Antibody in Immunohistochemistry (Paraffin) (IHC (P))

Search
Proteintech
MLK2 Polyclonal Antibody
{{$productOrderCtrl.translations['antibody.pdp.commerceCard.promotion.promotions']}}
{{$productOrderCtrl.translations['antibody.pdp.commerceCard.promotion.viewpromo']}}
{{$productOrderCtrl.translations['antibody.pdp.commerceCard.promotion.promocode']}}: {{promo.promoCode}} {{promo.promoTitle}} {{promo.promoDescription}}. {{$productOrderCtrl.translations['antibody.pdp.commerceCard.promotion.learnmore']}}
产品信息
19974-1-AP
种属反应
已发表种属
宿主/亚型
分类
类型
抗原
偶联物
形式
浓度
规格
纯化类型
保存液
内含物
保存条件
运输条件
产品详细信息
The antibody recognizes the N-term of MAP3K10. The antibody has no cross reaction to MAP3K9.
靶标信息
MAP3K10 (MLK2) is a serine/threonine kinase which has been shown to activate MAPK8/JNK and MKK4/SEK1. This kinase itself can be phoshorylated, and is thus activated by JNK kinases. MAP3K10 functions preferentially on the JNK signaling pathway, and is reported to be involved in nerve growth factor (NGF) induced neuronal apoptosis.
仅用于科研。不用于诊断过程。未经明确授权不得转售。
生物信息学
蛋白别名: MAP3K9; MEKK9; Mitogen-activated protein kinase kinase kinase 10; Mixed lineage kinase 2; MKN28 derived nonreceptor_type serine/threonine kinase; MKN28 kinase; MLK1; PRKE1; Protein kinase MST
基因别名: MAP3K10; MEKK10; MLK2; MST
UniProt ID: (Human) Q02779
Entrez Gene ID: (Human) 4294